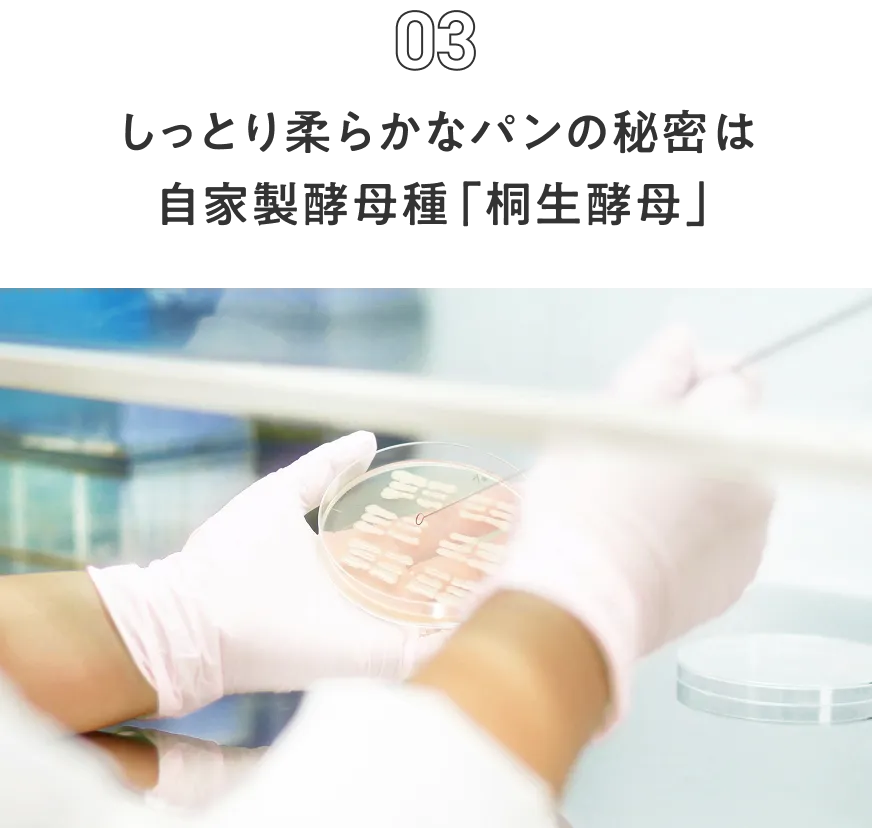

メルティ塩バターパン
バターがじんわり染みわたった塩バターパン。ひとつひとつ手作業でバターを巻き、丁寧に焼き上げています。生地には海洋深層水100%の国産塩を、トッピングにはアルプス岩塩を使用。


※スタイルブレッド公式オンラインストアを初めてご利用される方限定です。ご購入はお一人様1回限りとなります。
※こちらの商品は定期購入商品です。2回目以降は送料別となります。北海道、九州、沖縄へのお届けは別途エリア配送料を頂戴しております。

初回のお届けは送料無料
すでに会員登録がお済の方は ログイン 後、マイページより定期便のお申込み、および再開をお願いいたします。
※こちらの商品は定期購入商品です。2回目以降は送料別となります。北海道、九州、沖縄へのお届けは別途エリア配送料を頂戴しております。
素材と製法にこだわった上質なパンを、冷凍庫にストックできる安心感。焼きたての鮮度をそのまま閉じ込めて直送するから、ひとくち食べれば外はカリッと、中はふんわり。食べたいときにトースターで温めるだけで、ご家庭でいつでも焼きたての味を楽しめます。


バターがじんわり染みわたった塩バターパン。ひとつひとつ手作業でバターを巻き、丁寧に焼き上げています。生地には海洋深層水100%の国産塩を、トッピングにはアルプス岩塩を使用。

最大の特徴は何といってもベーコン。肉質の良いスペイン産豚バラ肉を無加水で加工し、桜のチップで燻した特注品です。着色料・燻液(燻製の風味づけができる食品添加物)は不使用。砂糖や塩でシンプルに調味し原材料を最小限に抑える事で、素材の持ち味を引き出しています。

はちみつがやさしく香る、ほんのり甘いもっちりパン。発売以来、圧倒的な人気を誇り、 販売累計個数はなんと370万個以上! 毎日食べても飽きのこない、スタイルブレッドを象徴するプティパンです。

外はパリッとサクサク、中はしっとりとした焼きたて食感のクロワッサンは、スタイルブレッド自慢の逸品です。芳醇なバターに包まれるひとときは、まさに至福。累計販売個数は120万個以上にのぼります。

国産小麦を100%使用し、小麦本来の風味が感じられる食事パン。外はパリっと中はふんわり、どんな料理にも合わせやすいパンです。甘味はほとんど無いので、ジャムともよく合います。

大人気のクロワッサンに、フランスヴァローナ社のバトンショコラを入れて焼き上げました。サクサク食感のクロワッサンからとろっと溶け出すチョコが絶品。甘さ控えめで、朝食にもぴったり。

水を一滴も使わず牛乳100%で練り上げた、ほんのり甘いプティパン。濃厚なフレッシュバターの香りがミルクの甘さを引き立てています。口溶けの良いソフトタイプなので、お子様のおやつにも。

国産小麦粉と全粒粉をブレンドし、豊かな香りをまるごと楽しむプティパン。表皮や胚芽がそのまま残っているため、粒々とした食感と香ばしさが特徴。一般的な全粒粉のパンに比べ、やわらかく軽い口当たりに仕上げています。


独自技術で氷の粒度を極小に留めることで、パンの細胞構造を壊さず、作りたての食感を維持しています。トースターで焼くだけで、ご自宅で一番美味しい状態のパンをお召し上がりいただけます。

作りたてのパンは、国内初の冷凍パン専用工場から直送しています。細菌が活動できない−18℃以下の環境で冷凍保管されるため、保存料不使用のナチュラルなパンをお届けします。
オリジナルの群馬県産小麦から起こした自家製酵母を自社研究所で培養しています。この「桐生酵母」に含まれる乳酸菌の働きにより、生地の保湿性が優れたしっとりと柔らかなパンに仕上がります。


※スタイルブレッド公式オンラインストアを初めてご利用される方限定です。ご購入はお一人様1回限りとなります。
※こちらの商品は定期購入商品です。2回目以降は送料別となります。北海道、九州、沖縄へのお届けは別途エリア配送料を頂戴しております。

初回のお届けは送料無料
すでに会員登録がお済の方は ログイン 後、マイページより定期便のお申込み、および再開をお願いいたします。
※こちらの商品は定期購入商品です。2回目以降は送料別となります。北海道、九州、沖縄へのお届けは別途エリア配送料を頂戴しております。


トースターで焼くだけで味わえる、作りたての美味しさ。このサイズだからこそ、一気に熱が通りサクッとした絶妙な食感が生まれます。

星付きレストランや名立たる有名ホテルのシェフが使うプロ専用のパンとして、 多くの料理人から支持されています。現在では全国約5,000店以上のホテル&レストランなどから採用されています。

スタイルブレッドでは毎日の食卓にぴったりなシンプルで飽きのこない食事パンを多数取り揃えています。程よいサイズ感で料理との相性もよく、メインディッシュのつけ合わせやサンドイッチにもおすすめです。

2回目以降は、約50種の中からお好きな組み合わせで自由に選択可能です。定番の食事パンに加え、「ガイアの夜明け」で話題の塩パンや菓子パンなど、旬のパンもラインナップ。自分好みにカスタマイズできます。

やはりパン屋さんのパンは当日が美味しい!それが冷凍庫にそのままあるのが嬉しいし助かる。パン屋のパンを冷凍させたものよりもスタイルブレッドの方が美味しい。
元来面倒くさがりなので、パン屋に行くのも面倒くさい。その点、家に冷凍でパン屋より美味しいパンがあるのが非常にありがたい。冷凍なのに日持ちもする。
子供がスーパーのパンだと食べてくれないのに、パン屋さんに頻繁に買いに行っていたのですが、スタイルブレッドのパンは美味しいと食べてくれます。
レビュー総合評価
「はじめてパンセット」商品
公式オンラインストアレビューより(2025年12月時点)


※スタイルブレッド公式オンラインストアを初めてご利用される方限定です。ご購入はお一人様1回限りとなります。
※こちらの商品は定期購入商品です。2回目以降は送料別となります。北海道、九州、沖縄へのお届けは別途エリア配送料を頂戴しております。

初回のお届けは送料無料
すでに会員登録がお済の方は ログイン 後、マイページより定期便のお申込み、および再開をお願いいたします。
※こちらの商品は定期購入商品です。2回目以降は送料別となります。北海道、九州、沖縄へのお届けは別途エリア配送料を頂戴しております。


ご注文フォームからお申し込み

ご指定の日に冷凍便でお届け

そのままトースターで焼くだけ

|
累積 購入回数 |
次回購入時の 割引率 |
|
|---|---|---|
| ランク1 | 1回 | 1% |
| ランク2 | 2〜3回 | 2% |
| ランク3 | 4〜5回 | 3% |
| ランク14 | 26〜27回 | 14% |
|---|---|---|
| ランク15 | 28〜29回 | 15% |
| ランク16 | 30回 | 16% |
ランクは退会するまで永久に適用されます。

入会費・年会費はかかりません。ライフスタイルに合わせて定期便のスキップや解約もいつでも可能です。
解約に制限はありません。マイページよりお手続きいただけます。
「スキップ」ボタンをクリックするだけで、次回のお届けスキップも簡単にできます。
「はじめてパンセット」のセット内容を個別に変更することはできません。2回目以降はお好きなパンの追加・変更が可能です。初めからお好きなパンを選んで、定期購入を始めることも可能です。
好きなパンを選んで定期購入をはじめる
お届けする段ボールは女性が一抱えできるサイズ(幅34cm×高さ18cm×奥行24cm)です。
※次回購入の際、商品追加をすると箱のサイズが変わる場合がございます。
パンを食べる頻度に合わせて、お届けサイクルが選べます。後でマイページから変更もできます。

約50種の冷凍パンが定期購入できる、通販サイトです。
入会費・年会費は0円。スキップや解約はいつでも可能ですので、ライフスタイルに合わせて、自由にパンをお選びいただけます。つくりたての新鮮なパンをあなたの冷凍庫に直接お届けします。
「年会費・入会費は0円」
「スキップや解約はいつでもOK」